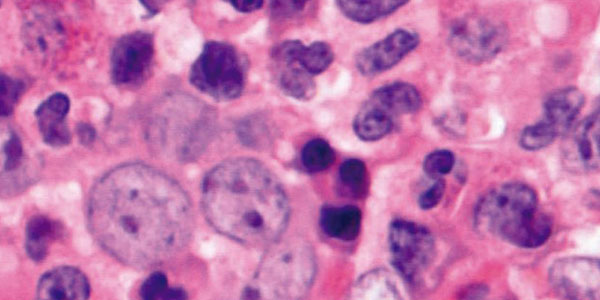

Laboratorios de primer nivel
En Centro Médico de Xalapa nos tomamos muy en serio nuestra labor de ser un referente en cuanto servicios de salud se trata, por esa razón nuestros laboratorios cuentan con más de 800 pruebas entre estudios de rutina y pruebas especiales.
Dentro de los retos que tienen nuestros laboratorios está el de ofrecer a los pacientes la más alta calidad en el servicio, por ello contamos con la certificación PACAL, un programa que le asegura a nuestros pacientes la calidad en los laboratorios con los que contamos.
Más de
800
Pruebas de rutina y pruebas especiales

Hematología
• Biometría hemática completa
• Grupo sanguíneo y factor Rh
• Investigación de células L. E.
• Tiempo de protrombina
• Tiempo de Tromboplastina
• Dímero D
Copros y Orinas
• Examen general de orina
• Coprológico
• Investigación de sangre oculta
en heces
• Coproparasitoscópico
• Investigación de amiba en
fresco
• Citología de moco fecal

Bioquímica
• Química sanguínea completa
• Pruebas de función hepática
• Electrolitos séricos
• Enzimas cardiacas
• Enzimas pancreáticas
• Gasometrías

Microbiologia
• Cultivo cérvico-vaginal
• Cultivo uretral
• Cultivo ótico
• Cultivo de herida
• Cultivo de expectoración
• Urocultivo
• Espermocultivo
• Coprocultivo

Hormonas
• Perfil tiroideo
• Perfil ginecológico
• Antígeno prostático
• Fracción β cuantificada
• Determinación de cortisol
• Insulina (basal y postcarga)

INMUNOLOGIA
• Prueba de embarazo
• Ac anti dengue
• Ac anti VIH
• Ac Anti helicobacter pylori
• Panel viral de hepatitis
• Prueba de inmunidad
2019n -Cov2 (Covid)
• Perfil reumático
